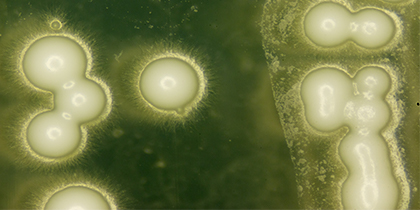

- December 12, 2022Students from the Horizon Centre for Doctoral Training (CDT) were hosted by the Cobot Maker Space to present their visions…
- October 19, 2022We are delighted to be hosting an ACI workshop 'Designing for Trust Autonomous Animal-Centric Robotic & AI Systems' led by…